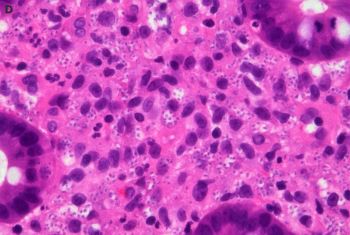

Case History
65 yo male with history of bone marrow tx for multiple myeloma presents with abdominal pain and diarrhea. Colonoscopy showed inflamed mucosa with ulcerations and polypoid lesions.
The most likely diagnosis is:
A. Severely active inflammatory bowel disease
B. Malakoplakia
C. Disseminated histoplasmosis
D. Acute bacterial colitis

The correct answer is: C. Disseminated Histoplasmosis.
Histoplasma capsulatum is a dimorphic fungal organism found on all continents inhabited by mankind. North American areas with the highest prevalence include the Mississippi and Ohio River Valleys. However, organism location is evolving due to climate change and manmade alterations in land use.
Infected individuals can exhibit symptoms similar to those seen in a spectrum of disease entities including pneumonia (community acquired and tuberculoid), Crohns disease, and sarcoidosis. While both immunocompetent and immunocompromised individuals are at risk for disease, most severe cases occur amongst the immunocompromised (HIV/AIDS, bone marrow transplantation, TNF-α inhibitors, etc).
Progressive disseminated histoplasmosis is characterized by fungal involvement of extrapulmonary sites. It is much more common in the immunocompromised (particularly those on TNF-α inhibitors). Patients tend to present with weight loss, fever, night sweats and pulmonary symptoms. The most common extrapulmonary sites of involvement are bone marrow, liver, spleen, and the GI tract.
Microscopically, Histoplasma appears as ovoid fungal organisms with narrow based budding. H. capsulatum variant capsulatum is roughly 2-4 micrometers in length. Histoplasma capsulatum variant duboisii is endemic to Africa, 6 to 12 micrometers, and can appear spherical. Organisms can often be found in macrophages and associated with granulomatous inflammation. Microscopic diagnosis can be made from tissue sections (H&E and special stains such as GMS and PAS) as well as microscopy of body fluids like bronchoalveolar lavage specimens. The gold standard for diagnosis is microscopic recognition in tissue/body fluid specimens as well as culture at room temperature. Supportive laboratory studies include urine Histoplasma antigen testing (most sensitive in disseminated and acute pulmonary cases), antibody serologic testing (not as useful for acute cases), and PCR based assays (variable sensitivity/specificity and no current FDA approved assays).
Medical management of progressive disseminated histoplasmosis consists of multiple weeks of liposomal amphotericin B with step down therapy (usually itraconazole) once response to treatment has been established.
Reference: Current Concepts in the Epidemiology, Diagnosis, and Management of Histoplasmosis Syndromes. Marwan M. Azar, et al. Semin Respir Crit Care Med 2020;41:13–30.